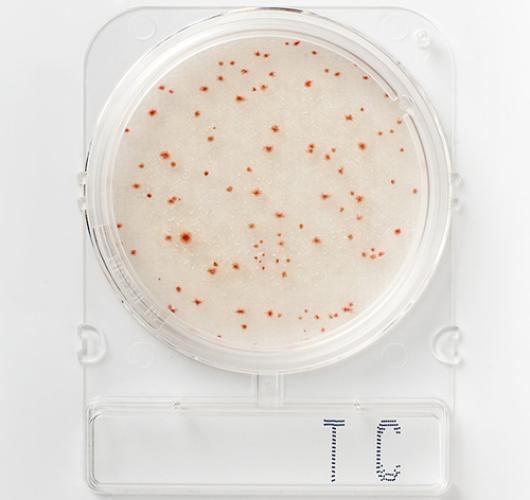
Подложки общее микробное число - Compact Dry TС

Подложки общее микробное число - Compact Dry TС
Подложки общее микробное число - Compact Dry TС
Соответствует правилам Управления по санитарному надзору за качеством пищевых продуктов и медикаментов (FDA); продукты питания (замороженные, охлажденные, предварительно приготовленные и подготовленные) в качестве одного из параметров анализа образцов фармацевтических препаратов и нутрицевтиков.
Для обеспечения безопасности пищевых продуктов необходимо провести анализ общего количества жизнеспособных микроорганизмов, чтобы подтвердить, что образец продукта питания или напитка не содержит микробных патогенов.
Все жизнеспособные колонии, образующиеся на хромогенных средах, имеют красный цвет, что позволяет их легче идентифицировать и отличить от возможных остатков пищи.
Цвет колоний: красный.
Температура и время инкубации: 35 +/- 1°C (AOAC), 30 +/- 1°C (MicroVal / NordVal)
Срок годности: 24 месяца / при 1–30°C.